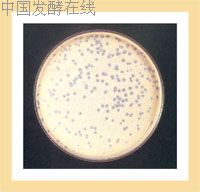

噬菌体的发现和研究历史
2006-10-10 22:39:51 来源:本站原创 评论:0 点击:
噬菌体
噬菌体(Bacteriophage)是一类侵害细菌(包括放线菌、真菌和原核生物)的病毒,又称细菌病毒(bacterialvirus)。具有其它病毒的共同特性:个体小、可通过除菌滤器、没有细胞结构、非常专一的寄生性等,为非细胞生物。其结构主要由蛋白质和核酸(DNA或RNA)组成。在自然界中分布广泛,土壤、空气、水中或生物体内都可存在。据噬菌体与宿主细胞的关系可分为烈性噬菌体(virulent phage)和温和噬菌体(temperate phage)两类。前者改变宿主的性质,大量产生新的噬菌体,最后导致菌体裂解死亡;后者可因生长条件的不同,即可引起宿主细胞的裂解死亡,又可将其核酸整合到细菌的染色体上,使细菌细胞继续生长繁殖,并被溶原化。据噬菌体的核酸类型、粒子形状和有无囊膜存在,可将其分为12个科。
噬菌体的危害
主要存在于发酵工业。如乳制品、酶制剂、氨基酸、有机溶剂、抗生素、微生物农药和菌肥生产等。一旦发生噬菌体污染,会导致发酵异常、倒罐,使工业生产遭到严重损失。

噬菌体的应用
1. 用于鉴定细菌的分型;
2. 分子生物学领域的重要实验工
具和最理想的材料;
3. 用于预防和治疗传染性疾病; 4. 用于筛选抗癌物质和检测致癌
物质;
5. 测定辐射剂量;
6. 检测植物病原菌。
噬菌体的防治
1.消灭噬菌体的各种来源(定期检查噬菌体,消除死角和隐患,改进空气过滤器和过滤材料);
2.选育抗噬菌体的菌株;
3.轮换使用生产菌株;
4.利用药物进行防治;
5.挽救损失(及早发现噬菌体的存在,可通过适当补加营养,接入抗性菌株细菌病毒的种类很多,现介绍几种主要的噬菌体肠道菌噬菌体
有伤寒菌、痢疾菌、肠球菌、大肠杆菌、变形杆菌、绿脓杆菌、链球菌和葡萄球菌等噬菌体。常存在于患者的粪便、医院污水、临床标本及外科病房脓液等。
主要用途:1.细菌的感染治疗。用上述各种噬菌体的混合制剂局部外用或口服治疗因耐抗生素等而久治不愈的患者。如:术后绿脓杆菌感染、菌痢患者大肠杆菌感染以及呼吸道的金黄色葡萄球菌感染绿脓杆菌噬菌体PY051金黄色葡萄球菌噬菌体EW福氏志贺氏菌痢疾噬菌体。





丙酮丁醇梭菌噬菌体(Clostridium acetobutylicum phage)
在丙酮丁醇连续发酵的工业生产中,容易受到该噬菌体的侵染,危害极大。常见的异常发酵有:发酵停止,不产生气泡,醪液上层澄清,呈暗黑色,出现睡眠症。正常发酵12-18小时,丙酮产量可达200mg/L,异常发酵时达到相同水平则需36-42小时,丁醇量也偏低 ,醪液的蒸馏效率低于正常的10-20%。现分离获得的丙酮丁醇梭菌噬菌体为肌尾和长尾噬菌体科。
钝齿棒杆菌噬菌体
钝齿棒杆菌(T6-13)是国内广泛用于谷氨酸生产的菌株,采用此菌及其相近菌株生产的环境中,普遍发生噬菌体的污染。导致生产延滞或产酸降低,甚至倒罐,给味精生产造成较严重的损失。
目前国内分离的噬菌体在形态上相似。根据血清学可分成两型:
B271和B275,有四种类型的噬菌斑。为防止噬菌体的侵袭,可在了解菌株对不同噬菌体的敏感性情况下,轮换使用不同菌株,以避免生产被迫停顿。
苏云金芽孢杆菌噬菌体
利用昆虫病原细菌—苏云金芽孢杆菌防治农林害虫已在国内外广泛应用和推广。但在生产过程中易受到噬菌体的侵染,严重地影响了细菌农药的生产和应用。
苏云金芽孢杆菌噬菌体的特征:头部为多面体,有颈部,尾部由尾管和尾鞘组成。
在pH6.0—7.0较稳定,60℃处理易失活,但能抵抗紫外线,照射60秒仍有42%的存活。
丙酮丁醇梭菌噬菌体CA1 和CA3 Clostridium acetobutylicum Phage CAI and CA3(图1)
钝齿棒杆菌噬菌体B271 Corynebacterium crenatum Phage
苏云金芽孢杆菌噬菌体TP33 Bacillus thuringiensis Phage TP33



红霉素链霉菌噬菌体(Streptomyces erythreus phage)
红霉素发酵液污染噬菌体后,往往在数小时至十几小时突然出现发酵液变稀,氨态氮上升,PH值升高,菌丝自溶,细胞破碎,一般噬菌体数可达1010pfu/ml以上。均为有尾噬菌体科。
λ噬菌体—理想的克隆载体
由于噬菌体的结构比细菌和高等细胞简单,故广泛用于复制、转录和调节机理的研究。而λ载体在分子克隆中扮演着重要角色。
λ噬菌体以前噬菌体方式存在于大肠杆菌K12株系中,利用紫外线诱导可以释放λ噬菌体,可感染已经丧失了λ噬菌体的大肠杆菌株系。其头部呈等轴的20面体,直径约54nm,主要由衣壳蛋白组成。尾部无尾鞘,长150nm。λ噬菌体颗粒的分子量为59.5×106道尔顿,线状双链DNA分子,由48,502bp组成。
λ噬菌体在大肠杆菌中繁殖有两条途径:裂解生长或整合到宿主染色体中复制。因λ噬菌体具有:
⑴λ-DNA可在体外包装成病毒颗粒,高效地感染大肠杆菌;
⑵可以把25Kb长的外源DNA插入λ-DNA,引入受体细胞;
⑶重组λ-DNA的筛选和保藏较易,故常作为分子克隆的载体。
红霉素链霉菌噬菌体P13, P8和P9 Streptomyces erythreus Phage P13, P8 and P9
大肠杆菌噬菌体λ Escherichia coli Phageλ
大肠杆菌丝状噬菌体fd E.coli filamentous Phage fd



噬菌体展示技术(Phage display techniques)
一般使用丝状噬菌体,它是将外源基因插入到噬菌体展示载体上,并使其与编码噬菌体外壳蛋白基因相连接,从而使外源基因编码的多肽或蛋白质与外壳蛋白以融合蛋白形式展示在噬菌体表面,被展示的多肽蛋白可保持相对独立的空间结构和生物活性。
噬菌体展示是一种基因表达和表达产物亲和选择相结合的技术。常以一组随机多肽编码序列或基因群体插入噬菌体展示载体,形成噬菌体展示文库。其文库中,每个噬菌体粒子只展示一种序列的外源肽链,不同噬菌体粒子展示不同序列的外源肽链。可采用亲和选择方法,高效挑选出带有外源基因的重组噬菌体,并利用这些噬菌体再感染大肠杆菌,扩增。还可从重组噬菌体DNA中切出外源基因再克隆到其它宿主细胞中,经表达以获得大量外源基因产物。
该技术兴于20世纪90年代初,由于其简化了抗体库构建及单克隆抗体的筛选过程,很快应用于人工抗体制备方面,并迅速扩展到生物学等其他许多领域。
相关热词搜索:噬菌体
上一篇:多肽抗生素
下一篇:维生素类药物出口形势分析与预测
评论排行
- ·中国发酵企业数据库(4)
- ·(4)
- ·CoQ10高产菌株选育的研究进展(2)
- ·抗生素发酵工艺所用冷却塔的性能分析及处理(1)
- ·微生物菌种选育技术.rar(1)
- ·发酵生产染菌及其防治(1)
- ·赤藓糖醇发酵工艺研究(1)
- ·重组AiiA 蛋白可溶性表达及发酵条件优化(1)
- ·生物反应器设计软件_发酵罐绿色版(1)
- ·酵母粉、酵母浸粉的区别(1)
- ·雷帕霉素研究进展(1)
- ·透明质酸用途和行业概况(1)
- ·黄酒制作工艺(1)
- ·水解(酸化)工艺与厌氧发酵的区别(1)
- ·糖蜜酒精废液处理过程中产生的微生物蛋...(1)
- ·紫杉醇高产菌发酵产物的分离、纯化和鉴定(1)

